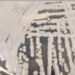
Superfungo: RN confirma primeiro caso de Candida auris em paciente

Uma adolescente de 17 anos foi morta e uma mulher de 54 anos ficou ferida após um ataque a tiros registrado na madrugada desta quinta-feira (5) no município de Arez, na região Agreste do Rio Grande do Norte. O crime é tratado pela polícia como feminicídio e tentativa de feminicídio, e o principal suspeito é o ex-namorado da jovem.
De acordo com a Polícia Militar, a ocorrência foi registrada por volta das 1h30, após moradores relatarem disparos de arma de fogo nas proximidades da Praça Getúlio Vargas, no centro da cidade.
Ao chegar ao local, equipes da PM foram informadas de que uma das vítimas havia sido levada para o hospital da cidade enquanto outra permanecia dentro de uma residência na Rua João Guiô.
Adolescente foi encontrada morta dentro de casa
No interior da casa, os policiais encontraram Emili Silva, de 17 anos, já sem vida. A jovem estava em um dos quartos da residência, sobre a cama, e apresentava duas perfurações no corpo provocadas por disparos de arma de fogo, segundo as informações iniciais da ocorrência.
O local do crime foi isolado para a realização da perícia pelo Instituto Técnico-Científico de Perícia (Itep).
A segunda vítima, Ana Menezes, de 54 anos, foi socorrida e levada ao hospital local. Conforme relato do médico plantonista à Polícia Militar, ela chegou à unidade ferida por disparos nas costas, no peito e no braço, mas estava estabilizada e sem risco imediato de morte.
Suspeito é ex-namorado da vítima
Segundo testemunhas ouvidas no local, o suspeito do crime seria um homem identificado apenas como “Igor”, ex-namorado de Emili. De acordo com relatos, o relacionamento entre os dois era considerado conturbado.
Ainda conforme as informações iniciais, o suspeito teria invadido o imóvel armado com uma arma de fogo curta e efetuado disparos contra as duas mulheres.
Após o ataque, ele teria fugido em direção ao distrito de Patané.
Equipes da Polícia Militar realizaram diligências na região durante a madrugada, com apoio de policiais de Senador Georgino Avelino, mas o suspeito ainda não havia sido localizado até a última atualização da ocorrência.
A Polícia Civil foi acionada e ficará responsável pela investigação do caso.
Imagem: Reprodução
Fonte: Novo Notícias





































![[VÍDEO] Seis suspeitos são presos durante operação contra facção ligada a homicídios no RN](https://www.jolrn.com.br/wp-content/uploads/2026/06/IMG_6349-360x180.webp)